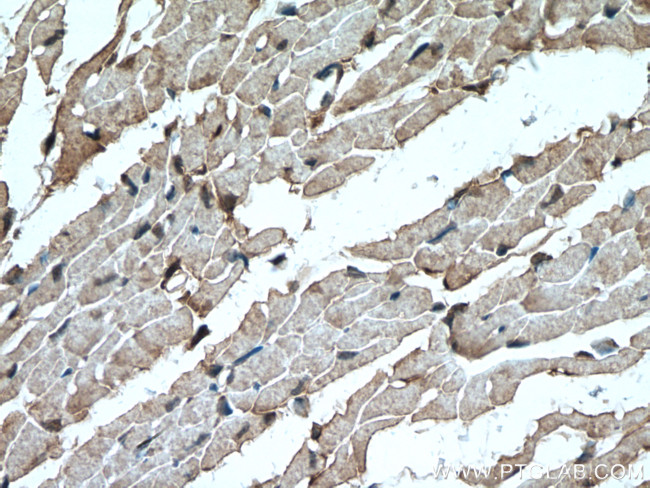
FADS2 Antibody in Immunohistochemistry (Paraffin) (IHC (P))

Search
Proteintech
FADS2 Polyclonal Antibody
{{$productOrderCtrl.translations['antibody.pdp.commerceCard.promotion.promotions']}}
{{$productOrderCtrl.translations['antibody.pdp.commerceCard.promotion.viewpromo']}}
{{$productOrderCtrl.translations['antibody.pdp.commerceCard.promotion.promocode']}}: {{promo.promoCode}} {{promo.promoTitle}} {{promo.promoDescription}}. {{$productOrderCtrl.translations['antibody.pdp.commerceCard.promotion.learnmore']}}
产品信息
28034-1-AP
种属反应
宿主/亚型
分类
类型
抗原
偶联物
形式
浓度
规格
纯化类型
保存液
内含物
保存条件
运输条件
产品详细信息
Immunogen sequence: MGKGGNQGE GAAEREVSVP TFSWEEIQKH NLRTDRWLVI DRKVYNITKW SIQHPGGQRV IGHYAGEDAT DAFRAFHPDL EFVGKFLKPL LIGELAPEEP SQDHGKNSKI TEDFRALRKT AEDMN (1-124 aa encoded by BC009011)
靶标信息
The protein encoded by this gene is a member of the fatty acid desaturase (FADS) gene family. Desaturase enzymes regulate unsaturation of fatty acids through the introduction of double bonds between defined carbons of the fatty acyl chain. FADS family members are considered fusion products composed of an N-terminal cytochrome b5-like domain and a C-terminal multiple membrane-spanning desaturase portion, both of which are characterized by conserved histidine motifs. This gene is clustered with family members FADS1 and FADS2 at 11q12-q13. 1; this cluster is thought to have arisen evolutionarily from gene duplication based on its similar exon/intron organization.
仅用于科研。不用于诊断过程。未经明确授权不得转售。
生物信息学
蛋白别名: Acyl-CoA 6-desaturase; D6D; delta(6) desaturase; Delta(6) fatty acid desaturase; delta-6 desaturase; delta-6 fatty acid desaturase; delta-6-desaturase; Fatty acid desaturase 2; linoleoyl-CoA desaturase (delta-6-desaturase)-like 2; unnamed protein product
基因别名: 2900042M13Rik; D6D; DES6; FADS2; Fadsd2; FADSD6; LLCDL2; SLL0262; TU13
UniProt ID: (Human) O95864, (Mouse) Q9Z0R9
Entrez Gene ID: (Human) 9415, (Mouse) 56473